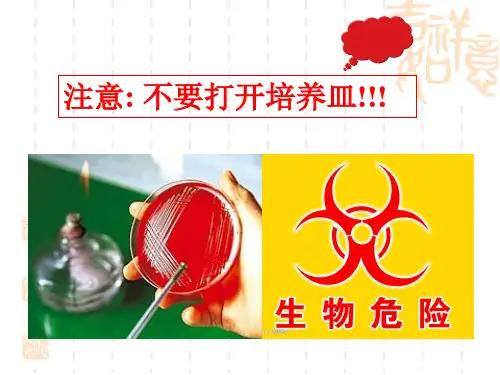

MS—D活性糖对肠道菌生长及部分生物学特性影响的初步探究
- 格式:pdf
- 大小:358.15 KB
- 文档页数:6

适合于个性化培养的红茶菌发酵综合性实验目录一、实验概述 (2)1.1 实验目的与意义 (2)1.2 实验原理与简介 (4)1.3 实验材料与设备 (4)1.4 实验步骤与流程 (5)二、红茶菌的培养基础 (7)2.1 红茶菌的起源与历史 (8)2.2 红茶菌的营养成分与保健功能 (9)2.3 红茶菌的培养方法与条件 (11)2.4 红茶菌菌种筛选与鉴定 (12)三、个性化培养策略 (14)3.1 个性化培养的概念与特点 (15)3.2 培养基的选择与配置 (16)四、红茶菌发酵过程 (17)4.1 发酵过程中的化学变化 (18)4.2 发酵过程中微生物群落的变化 (20)4.3 发酵过程中理化性质的变化 (21)4.4 发酵过程中感官品质的变化 (22)五、实验结果与分析 (23)5.1 实验数据的收集与处理 (25)5.2 数据分析方法与应用 (26)5.3 实验结果与讨论 (28)5.4 发酵效果的评价标准与方法 (30)六、实验总结与展望 (31)6.1 实验的主要成果与收获 (32)6.2 实验的不足之处与改进措施 (33)6.3 对未来研究的建议与展望 (34)6.4 实验报告撰写与提交要求 (35)一、实验概述红茶菌发酵是红茶品质形成的关键环节,其中微生物群的丰富性及多样性直接影响着最终茶叶的风味、色泽和香气等品质指标。
该实验旨在建立一套个性化培养红茶菌的发酵体系,通过对不同菌株的筛选、组培、培养工艺优化等环节进行深入研究,探索个性化红茶菌组合及发酵条件对红茶品质的影响规律。
该实验将结合传统发酵经验与现代生物技术,通过分析菌群结构、代谢产物、发酵动态等指标,构建一套可度量、可控、可调控的个性化红茶菌发酵模式,为红茶产业提供新思路,推动红茶品质向更精细化、个性化方向发展。
1.1 实验目的与意义本实验旨在通过红茶菌的发酵培养,探索不同条件对红茶菌生长、代谢产物产生以及最终产品品质影响的研究。

大肠杆菌的代谢途径及相关蛋白大肠杆菌是一种广泛存在于自然界中的革兰氏阴性菌。
它是一种典型的肠道菌,在人类和动物的肠道里广泛分布,对人类、动物和环境都有一定的影响。
大肠杆菌依赖于六个基本代谢途径来生存和繁殖。
本文将介绍大肠杆菌的代谢途径以及相关蛋白。
1. 糖代谢途径糖代谢途径是大肠杆菌最重要的代谢途径之一。
这个途径可以使大肠杆菌利用多种不同的糖类,包括葡萄糖、果糖、半乳糖等。
当大肠杆菌进入宿主的肠道时,糖类是它最主要的能量来源之一。
在大肠杆菌的糖代谢途径中,葡萄糖的代谢是最主要的,其中需要的蛋白质有:(1)葡萄糖转运蛋白它是葡萄糖分子在胞外和胞内之间运输的主要通道。
它可以将细胞外的葡萄糖转运到细胞内,以供后续的代谢。
(2)磷酸果糖激酶它可以催化糖类在细胞内的反应,将葡萄糖进行磷酸化,从而催化后续的糖酵解反应。
(3)乳酸脱氢酶它可以催化乳酸代谢途径中的反应,将葡萄糖进行进一步分解,转化为乳酸,同时释放氢离子和电子。
2. 脂肪酸代谢途径脂肪酸代谢途径是指将脂肪酸分解成为能够提供动力的产物,从而为细胞提供能量。
脂肪酸代谢途径中需要的蛋白质有:(1)酰基辅酶A合成酶它可以催化脂肪酸与辅酶A酰化的反应,使之生成酰基辅酶A,在肝细胞中起重要作用。
(2)酮基酸脱羧酶它可以催化脂肪酸酶催化的酮基酸以及氧去除的反应,将之转化为脂肪酸。
(3)反式脂肪酸酶它是重要的β-氧化酶,可以催化反式脂肪酸的转化为正式脂肪酸。
3. 氨基酸代谢途径氨基酸代谢途径指的是将蛋白质分解产生的氨基酸进行代谢,从而获得能量和合成重要物质的过程。
氨基酸代谢途径中需要的蛋白质有:(1)谷氨酸脱氢酶它可以催化谷氨酸脱氢反应,将谷氨酸转化为酰谷氨酸。
(2)天门冬氨酸转氨酶它可以催化天门冬氨酸转基反应,将天门冬氨酸与α-酮酸转化为酪氨酸或丙酮酸。
(3)脯氨酸脱羧酶它可以催化脯氨酸脱羧反应,将脯氨酸转化为丙酮酸和亚硫酸成分。
总的来说,大肠杆菌的代谢途径有很多,每一种代谢途径都需要多种不同的蛋白质来协同工作。



D()I:10. 13350/j.cjpb.201103•论著•一株牛源致病性蜡样芽孢杆菌的分离鉴定与部分生物学特性分析<霍晓伟、宋扬、刘杰2,范培超\史量全、蒙小刚\刘锴、温树波h •,鲁会军〃 •(1.内蒙古民族大学动物科学技术学院,内蒙古通辽〇28042;2.吉林农业大学动物科学技术学院;3.军事科学院军事医学研究院军事兽医研究所)【摘要】_____目的分离鉴定牛源致病性蜡样芽孢杆菌,并分析其部分生物学特性。
方法科用P C R方法检测猝死西门塔尔病牛各组织脏器中常见病毒感染情况,同时做涂片镜检,分离感染的细菌,通过形态学观察、生化检测、药敏试验、16S r R N A基因序列分析、毒力基因扩增、动物致病性实验等对分离菌进行鉴定及部分生物学特性分析。
结果从猝死牛肝脏中分离到1株革兰阳性蜡样芽孢杆菌,将其命名为T L-19,该菌株含有en t F M、n h eB、h b l D、n b l A、n h e C、n h eA、h b l C和c y t k等毒力基因,且对小鼠具有较强的致病性,感染鼠24 h后全部死亡。
结论成功分离到1株牛源蜡样芽孢杆菌T L-19。
该菌含有多种毒力基因,通辽市西门塔尔牛猝死与该T L-19感染有关。
蜡样芽孢杆菌;细菌生化实验;药敏实验;致病性关键词】I中图分类号】R378. i【文献标识码】A【文章编号】1673-5234(2020)11-1252-05[^Jour?ial o f Pathogen B io lo g y.2020 N o v;15(11):1252-1256.]Identification and analysis of the biological characteristics of a ce/TMs strain from cattleHU()Xiao-wei1,SONG Yang1,LIU Jie—,FAN Pei-chao1,SHI Liang-quan1,MENG Xiao-gang1,LIU Kai'^WEN Shu-bo1»LU Hui-jun(1. College o f A n i m a l Science a n d T echnology ^Inner M ongolia U niversity f o r N ationalitie s ^TongliaO', Inner Mu?igolia ^China028042;2. College o f A n i m a l Science a n d Technology^ J i l i n A g r ic u ltu r a l U niv ersity;M i li t a r y V eterinary Institute-, A c a d e m y o f M i li t a r y M edical Science)【Abstract】acteristics.Objective T o isolate and identify pathogenic Bacillus cereus f r o m cattle and to analyze its biological char- M e t h o d s P C R w a s used to detect c o m m o n bovine viral infections in various organs. A s m e a r test under m icroscope a nd pure culture w e r e performed to isolate a bacterial strain fro m the liver sample of cattle that died suddenly. T h e m o r p h o l o g y of the strain w a s e x a m i n e d and i t w a s subjected to biochemical testing and a drug sensitivity tests* the 16S r R N A gene w a s sequenced* virulence genes w e r e detected, and a m o u s e pathogenicity tests w a s performed to identify and analyze the biological characteristics of the bacterium. Results A Gram-positive strain of B. c ereus,designated T L-19,w a s isolated f r o m the liver of S i m m e n t a l cattle that died suddenly. This strain w a s sensitive to clindamycin, ka- namycin, a nd ciprofloxacin but resistant to penicillin. N o parasporal crystals wer e f o r m e d o n spores of T L-19 in drug susceptibility testing or a parasporal crystal protein test. P C R revealed that T L-19harbors virulence genes* including en-t F M,n h e B,h b l D, 7iblA,n h e C,n h e A,h b l C,anA cytk •Pathogenicity analysis indicated that the bacterium w a s pathogenic to mice since all of the mice died 24 h after infection. Conclusion A strain of B. cereus designated T L-19,which contains several virulence genes, w a s successfully isolated, T h e sudden death of S i m m e n t a l cattle fro m a breeder in the City of Tongliao is p r e s u m a b l y related to this bacteriumB acillus c ereu s;biochemical tests;drug sensitivity test;pathogenicity蜡样芽胞杆菌MMW)是一种广泛分布于 土壤、水、空气等环境中的革兰阳性芽孢杆菌1]。

大肠杆菌感染机制及其生物学特性分析大肠杆菌是一种常见的革兰氏阴性菌,它是一种可以引起人类和动物的感染的病原体。
它所引起的感染可以从轻微的腹泻到严重的肠道感染及败血症等症状。
在这篇文章中,我们将详细分析大肠杆菌的感染机制及其生物学特性。
1. 大肠杆菌感染机制大肠杆菌感染机制分为三个部分:侵入宿主细胞、生长和繁殖以及抵抗宿主免疫系统。
侵入宿主细胞侵入宿主细胞是大肠杆菌引起感染的第一步。
大肠杆菌通过其生长在肠道内的菌落数量增加,导致其超过生理承受的限度并迁移到肠黏膜表面。
这时,大肠杆菌就会发出不同的信号,吸附并通过菌毛肢(fimbriae)等表面结构黏附到宿主肠上皮细胞上。
生长和繁殖大肠杆菌一旦进入宿主体内,就会在肠道内迅速繁殖。
其细胞壁上的LPS (lipopolysaccharide)含有的乙酰葡萄糖胺和脂多糖等分子可以与Toll样受体4(TLR4)结合,从而诱导一系列促炎性信号通路的激活。
这些免疫反应会导致炎症和肠胃道的损伤。
抵抗宿主免疫系统大肠杆菌还会利用某些因子,如产生溶菌素和胆碱酯酶等,来避免宿主免疫系统的攻击。
在感染早期,大肠杆菌会分泌胆结实素(bile salt hydrolase),分解溶菌素和胆酸等宿主体内的化合物,从而逃避宿主免疫机制的攻击。
此外,大肠杆菌还会分泌溶血素,使血液中的血清素分解为活性物质,从而导致免疫系统的抑制。
2. 大肠杆菌的生物学特性大肠杆菌是一种革兰氏阴性菌,其细胞壁上有内膜、外膜和一层薄膜,薄膜是一种醣基化脂肪酸,称为脂多糖。
在肠道内,大肠杆菌可以使用人体所消化的碳水化合物,如葡萄糖、果糖和半乳糖等。
同时,大肠杆菌还可以发酵人体无法吸收的多糖类成分,如木聚糖和纤维素等。
大肠杆菌是一种可以生长在不同的环境中的杆形菌,它可以在肠道内生长,也可以在水和土壤中生长。
大肠杆菌的生长速度非常快,每20分钟就可以分裂一次。
这种快速的生长速度使大肠杆菌变得非常适应不同的环境和细胞。


【收稿日期】2009-02-15【作者简介】廖宁波(1982-),男,硕士研究生,从事肠道微生态学,E m a i l :8150060@163.c o m ;王欣,通讯作者文章编号:1005-376X (2009)05-0477-03【综 述】肠道内分节丝状菌的生物学特性及其与宿主黏膜免疫系统的关系廖宁波1,孙国昌2,王欣2(1.浙江师范大学化学与生命科学学院,浙江金华 321004;2.浙江省农业科学院植物保护与微生物研究所,浙江杭州 310000)【关键词】 分节丝状菌;肠道微生态;肠道黏膜免疫系统【中图分类号】R 379.9 【文献标识码】A 脊椎动物肠道内存在着近千种,数量以百兆计算的细菌。
这些肠道细菌与脊椎动物共同进化了上亿年,建立了密切的互惠互利的关系。
对任何高等动物而言,实际上是动物本身和细菌的共和体[1]。
细菌能够大量存在动物肠道中的直接原因是因为这些细菌的基因库中包含了大量的功能基因,而且这些功能基因为宿主动物本身所不具有,能够为宿主提供一系列独特的、宿主缺乏而必须的生理功能。
分节丝状菌(S e g -m e n t e df i l a m e n t o u s b a c t e r i a ,S F B )是广泛存在于人、多种脊椎动物及无脊椎动物肠道内的一类形态结构特异的“原著”细菌。
这种细菌和宿主的免疫成熟息息相关,影响到宿主肠道黏膜免疫系统中s I g A 的分泌,从而引起了肠道微生物学家对该细菌研究的热情。
本文对S F B 的研究近况做一简要概括,着重介绍S F B 在宿主免疫调节与免疫成熟方面可能扮演的角色。
1 生物学特性1.1 生存环境及生活史 早在1849年L E I D Y 等人观察到在白蚁肠道内生长着一种微生物,其形状像植物纤维,L E I D Y 称之为“e n t e r i c f l o r a ”。
至上个世纪60年代,随着显微技术的发展,越来越多的人观察到这类菌群的存在,1965年H A M P T O N 等人根据形态学方面的独特特点,称其为F i l a m e n t o u s s e g m e n -t e dm i c r o -o r g a n i s m s ,之后又有学者称之为S e g m e n t e df l a m e n t o u sb ac t e r i a 简称S F B [2],1995年许益名等首次将其在国内的刊物中译为分节丝状菌[3]。

枣庄学院生命科学学院学年论文(本科生)题目: 双歧杆菌生物学作用及其应用学生姓名田茵茵指导教师李言秋专业生物科学级别2011级摘要目的:归纳总结双歧杆菌生物学作用及其研究进展。
方法:查阅了近年来的文献,综述了近年来对双歧杆菌研究的新进展。
结果:双歧杆菌具有免疫调节、抗肿瘤、抗感染、抗衰老、降血脂和营养保健等一系列特殊生理功能[1]。
结论:双歧杆菌具有多种生物学功能,有潜在的预防和治疗疾病的作用,在食品工业和药品开发领域具有广阔的前景。
关键词:双歧杆菌;生理特性;保健功能第1章引言双歧杆菌归属于放线菌科双歧杆菌属,专性厌氧,革兰氏阳性,成杆状,不形成芽孢,不运动。
因为它能发酵糖类,产生大量乳酸,又称为乳酸菌。
它可利用葡萄糖,乳糖,半乳糖和果糖。
一般将果糖作为碳源,将氮作为唯一可利用的氮源。
与人类相关的双歧杆菌菌株有:双歧杆菌Biovars a和b,长双歧杆菌Biovars a和b,婴儿双歧杆菌,短双歧杆菌,青春双歧杆菌Biovars a和b和c,梭形双歧杆菌,链状双歧杆菌,假链状双歧杆菌和齿状双歧杆菌[2]。
双歧杆菌是母乳喂养婴儿肠道内的优势菌,占母乳喂养婴儿粪便中总微生物群落总数的99%。
它也是成人肠道中占绝对优势的正常寄宿菌。
它可以存在于小肠,但数量比在大肠和粪便中少。
同时它也存在于人的口腔、阴道、许多动物的消化道,还可发现于污水中。
第2章双歧杆菌的生理特性2.1 形态双歧杆菌形态多变,因不同种,不同龄及不同生长环境而呈现多种形态。
有短杆较规则型或纤细杆状具有间隙末端的细胞,也有球形、棍棒状、匙型或多种分枝、分叉型,典型形态特征是具有分叉的杆菌[3]。
菌落光滑、凸圆、边缘完整,乳脂呈白色,闪光且质地柔软,由此而得名双歧杆菌[4]。
2.2 生活条件与生存特点双歧杆菌最适生长温度是37℃-41℃,在25℃-28℃或43℃-45℃也能生长。
初始生长PH6.5-7.0,在PH5.0或高于8.0不生长。
版权归本文作者所有,未经本人同意任何人不得修改挪用。
最终解释权归本文作者。
作者:郑昌兴(中国科学院大化所壳寡糖研究中心专家委员/中国海洋大学海洋药物研究中心特聘专家几丁聚糖100问前言糖类的研究已有百年的历史,许多研究成果表明,糖类是生物体内一类重要的信息分子。
生命科学研究的最新发现:现代疾病的发生根源是“细胞糖链结构受损”。
这是个全新概念。
这一发现是继基因组学、蛋白质组学研究之后生命科学探索的又一里程碑!研究发现,当人体细胞表层的糖链变化,细胞的本体也会随之变化。
细胞的生命过程是通过糖链传导而完成的,新发现映射出一个新结论:不是基因调节细胞,而是细胞表层的糖链在时刻地调控着细胞的状态。
同时糖参与了细胞生命变化的全部过程!这种糖并非我们所食用的葡萄糖或蔗糖,而是一种低聚糖,也称为小分子几丁聚糖;几丁聚糖是自然界中的一大类物质。
其中唯一带正电荷的几丁质聚糖(英文Chitooligosaccharides)在细胞生命过程中的作用则尤其突出。
它密集地覆盖在细胞的表层,起到信息传递、免疫调节、基因信息表达等作用,同时它也是细胞身份识别标志。
在自然界中,昆虫、海洋软体动物以及虾蟹壳中都含有几丁聚糖成分。
研究发现,现代疾病的发生与发展都与细胞表层的糖链结构损伤有着直接的关系;从另一个角度讲,只要细胞表层的糖链结构完整,细胞即可完成准确的表达过程或免疫过程。
因此,生物体就会保持健康的状态,不会生病;相反,如果细胞表层的糖链出现损伤,细胞免疫信号必然受到影响,这时细胞免疫就受到影响,甚至丧失免疫,临床中称为免疫力低下或免疫缺失。
以功能类比:如果把细胞比喻成人体,那么细胞表层的糖链非常类似于人体的神经组织,基因如同人的大脑;糖链是基因传导信息的载体组织,它是细胞的功能组织之一。
生命科学研究发现,人到中年后就完全丧失了自我合成几丁聚糖的机能,必须靠外援性补充,其中最关键的是从食物中获取。
现代生产模式的改变,尤其是大量使用农药以及大棚栽培,使产生几丁聚糖的途径断绝(昆虫灭绝),人体不能及时地补充几丁聚糖,使受损的细胞糖链得不到及时有效的修复,严重地影响了细胞的免疫功能。
开菲尔的生物学特性与活性功能研究进展开菲尔(Kefir)作为一种传统的发酵乳饮料,在国内外有悠久的饮用历史,它具有特殊的营养价值与保健功效,深受人们的喜爱。
国内外的学者、专家对其组成、活性功能及作用进行过许多研究,发现作为酿制开菲尔的发酵剂开菲尔粒(Kefir Grains,KG),能使开菲尔酸奶比普通酸奶营养更丰富、更易于消化,它的构成菌所分泌的许多发酵产物有生理保健功能,具有调节循环和呼吸系统功能、改善消化机能、提高钙的吸收利用等作用,尤其是开菲尔具有的抗氧化、降血压、降胆固醇、抗肿瘤等生理保健功能,已使其成为近年开发研究的热点。
同时也发现,开菲尔能分泌细菌素、抗菌肽、溶菌酶等天然抗菌物质,在食品工业、医药行业都非常值得开发利用。
1 开菲尔的起源及营养功效开菲尔是一种传统酒精发酵乳饮料,是以牛乳或山羊乳为原料,加入含有乳酸菌和酵母菌的开菲尔粒发酵剂,经发酵酿制而成[1]。
它与传统的酸乳或用其他纯种乳酸菌发酵剂所制成的产品相比较,最显著的特征是除乳酸发酵外,还伴有轻微的由酵母菌引起的酒精发酵,是一种集酸味、醇味于一体的发酵乳制品。
开菲尔起源于俄罗斯北高加索地区,在古时当地的山岳牧民将牛乳或山羊乳注入羊皮口袋经自然发酵生产酸乳酒,其残留物再补加牛乳或山羊乳继续发酵,经长期发酵后在皮口袋中形成不规则颗粒状物体,即为开菲尔粒。
此后人们便直接将开菲尔粒添加到牛乳中,使之发酵而生成具有爽快酸味和起泡性的酒精性保健饮料。
根据相关的研究报道,开菲尔发酵及成熟过程中,有益菌群会将牛乳中的乳糖大部分水解为对人体有益的L(+)乳酸,所以开菲尔含有容易被消化吸收的乳蛋白质和乳脂肪,对人体具有较高的营养价值[2]。
开菲尔等发酵奶中非蛋白质氮以及游离氨基酸的含量比普通牛奶多,游离氨基酸有脯氨酸、亮氨酸、赖氨酸、鸟氨酸、组氨酸等;碳水化合物丰富,主要有乳糖、半乳糖、葡萄糖以及微生物发酵产生的多糖;维生素主要有B族维生素,如B1、B2、B6、B12以及叶酸等,并有多种人体必需的矿物元素,如钙、镁、钾、磷、铁等,营养丰富,长期饮用后保健功效明显[3]。
大肠杆菌生化实验报告大肠杆菌生化实验报告引言:大肠杆菌(Escherichia coli)是一种常见的肠道细菌,广泛存在于人类和动物的消化系统中。
由于其简单的生长条件和高度适应性,大肠杆菌成为了许多生化实验的理想模型。
本报告旨在介绍大肠杆菌在生化实验中的应用和结果。
实验一:酶活性测定酶活性是衡量细胞代谢活跃程度的重要指标之一。
在本实验中,我们选择了大肠杆菌中的一种酶,β-半乳糖苷酶(LacZ),来进行酶活性测定。
实验步骤:1. 培养大肠杆菌细胞。
2. 采集细胞样品,并进行离心。
3. 悬浮细胞样品,并加入底物。
4. 反应一段时间后,停止反应,并测定底物的降解程度。
结果与讨论:通过测定底物的降解程度,我们可以得到β-半乳糖苷酶的酶活性。
实验结果显示,在不同培养条件下,大肠杆菌中的β-半乳糖苷酶酶活性存在差异。
这表明培养条件对细菌酶活性有一定的影响。
进一步的研究可以探究这些影响因素,并优化培养条件,提高酶活性。
实验二:代谢产物分析大肠杆菌是一种典型的乳酸菌,其代谢途径复杂多样。
在本实验中,我们选择了大肠杆菌中的乳酸代谢途径作为研究对象,通过代谢产物分析来了解细菌的代谢特征。
实验步骤:1. 培养大肠杆菌细胞。
2. 采集细胞样品,并进行离心。
3. 提取细胞内代谢产物。
4. 使用色谱或质谱等技术,对代谢产物进行分析。
结果与讨论:通过代谢产物分析,我们可以了解大肠杆菌在不同培养条件下的代谢特征。
实验结果显示,大肠杆菌在不同培养基中产生的代谢产物有所差异。
这表明培养基成分对细菌代谢途径的选择有一定的影响。
进一步的研究可以探究这些影响因素,并优化培养基配方,调控代谢途径,提高产物产量。
实验三:抗生素敏感性测试抗生素敏感性测试是评估细菌对抗生素的耐药性的重要方法之一。
在本实验中,我们选择了几种常用的抗生素,对大肠杆菌进行敏感性测试。
实验步骤:1. 培养大肠杆菌细胞。
2. 制备不同浓度的抗生素溶液。
3. 在琼脂平板上涂布细菌样品。
胃肠道微生物种群与人类消化系统疾病相关性研究进展刘德华;孙宝林【摘要】人体胃肠(GI)道附着有复杂且动态变化的微生物种群,即肠道菌群,它们对宿主的健康和疾病有着显著的影响.胃肠道细菌在维持人体免疫、代谢稳态以及预防病原体感染中发挥着至关重要的作用,其组成的改变与许多炎症和感染性疾病的发生有关.目前,大量研究揭示了不同微生物组对人类消化系统疾病的影响,如胃炎、炎症性肠病和癌症等.人体胃肠道微生物及其相关代谢产物也被认为是多种疾病的潜在治疗靶标.总结目前对人类胃肠道微生物群的组成和发展的理解,以及胃肠道微生物对胃肠道完整性和宿主健康与疾病的影响,这是人体-微生物相互作用的相关性研究的基础.【期刊名称】《生物学杂志》【年(卷),期】2019(036)004【总页数】6页(P1-6)【关键词】胃肠道;微生物群;代谢产物;消化系统疾病【作者】刘德华;孙宝林【作者单位】中国科学技术大学生命科学学院,合肥230026;中国科学技术大学生命科学学院,合肥230026【正文语种】中文【中图分类】R57胃肠(GI)道具有250~400 m2,是人体和环境因子及抗原的最大接触面之一[1] 。
在人的一生中,除了大约有60 t食物外,还有大量来自环境的微生物通过胃肠道,这些微生物对胃肠道的完整性产生了重要影响。
细菌、古生菌和真菌在消化道的集落统称为肠道微生物群,它们与宿主共同进化了数千年,形成了复杂而互利的关系。
据估计,人体消化道承载的微生物数量高达1014个,近乎人类细胞的10倍[2]。
通过16S rRNA基因测序方法检测肠道微生物组,发现肠道微生物基因数达500万,是人类基因组的150多倍[2] 。
因此,通常将宿主及寄生于其上的大量微生物称为超级有机体[3] 。
胃肠道作为具备代谢、免疫和内分泌功能的器官,可以与机体的其他器官相互作用、相互影响。
微生物群可以增强肠道完整性、塑造小肠上皮、获取能量、抵御病原体和调节宿主免疫等。
子痫前期与肠道菌群余婷;关德凤;张冬萍【摘要】肠道菌群是一个定植于人体肠道内的复杂且庞大的微生物群,可产生多种代谢产物,显著影响宿主生理、能量稳态、炎症过程和机体免疫功能,对维持机体健康发挥重大作用.近年肠道菌群的结构和生理功能、妊娠期肠道菌群变化、肠道菌群与妊娠期疾病的相关性已成为研究的热点.虽然子痫前期的病因和发病机制仍不明确,但大部分研究认为其可能与血管因素、免疫平衡失调、全身炎症反应因素有关.肠道菌群可能通过在血管因素、免疫反应、炎症反应等方面发挥作用,参与子痫前期的发生、发展.调整饮食结构及补充微生态调节剂能够调节肠道菌群紊乱,从而达到预防或改善子痫前期的作用,这为探索子痫前期的防治提供了新靶点和新思路.【期刊名称】《国际妇产科学杂志》【年(卷),期】2019(046)002【总页数】4页(P169-172)【关键词】先兆子痫;肠;微生物组;治疗【作者】余婷;关德凤;张冬萍【作者单位】730000 兰州大学第一临床医学院;730000 兰州大学第一临床医学院;730000 兰州大学第一临床医学院【正文语种】中文子痫前期是妊娠期特有疾病,可累及全身多个器官,是导致孕产妇及围生儿患病率和死亡率升高的主要原因之一,可影响2%~8%的孕产妇。
虽然近年因产前保健的普及以及临床诊治的规范化推广,子痫前期的发生率和妊娠期高血压疾病所致死亡率呈下降趋势,但大多数孕产妇的死亡仍与子痫前期有关。
全球每年约有5万孕产妇死于子痫前期或子痫[1]。
如英国,因子痫前期和子痫死亡者占孕产妇死亡的15%,其中有2/3与子痫前期有关[1]。
2014年Abalos等[2]报道妊娠期子痫前期、子痫和慢性高血压的发病率分别为2.16%、0.29%和0.28%。
因此,对于子痫前期仍需要足够重视。
正常妊娠时母体需经历一系列生理变化,以支持胎儿胎盘的生长,包括免疫、内分泌和代谢适应,同时肠道菌群及其代谢也会发生与宿主生理和免疫适应相关的变化[3]。